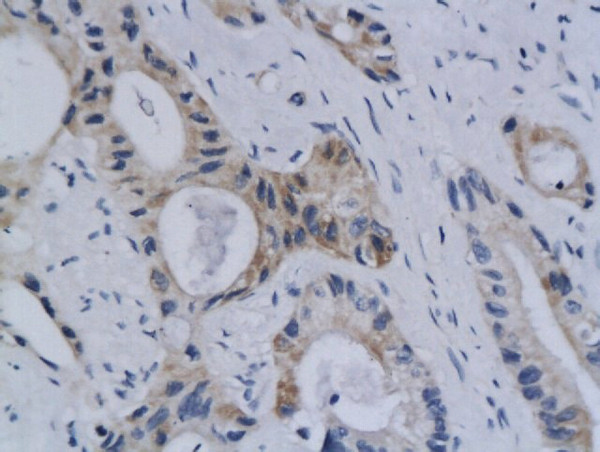
Styk1 Antibody in Immunohistochemistry (Paraffin) (IHC (P))

Search
Bioss
Styk1 Polyclonal Antibody
{{$productOrderCtrl.translations['antibody.pdp.commerceCard.promotion.promotions']}}
{{$productOrderCtrl.translations['antibody.pdp.commerceCard.promotion.viewpromo']}}
{{$productOrderCtrl.translations['antibody.pdp.commerceCard.promotion.promocode']}}: {{promo.promoCode}} {{promo.promoTitle}} {{promo.promoDescription}}. {{$productOrderCtrl.translations['antibody.pdp.commerceCard.promotion.learnmore']}}
产品信息
BS-5957R
种属反应
宿主/亚型
分类
类型
抗原
偶联物
形式
浓度
规格
纯化类型
保存液
内含物
保存条件
运输条件
靶标信息
STYK1, a probable tyrosine protein-kinase, which has strong transforming capabilities on a variety of cell lines. When overexpressed, it can also induce tumor cell invasion as well as metastasis in distant organs. May act by activating both MAP kinase and phosphatidylinositol 3'-kinases (PI3K) pathways. It is widely expressed; highly expressed in brain, placenta and prostate. STYK1 is expressed in tumor cells such as hepatoma cells LO2, cervix carcinoma cells HeLa, ovary cancer cells Ho8910 and chronic myelogenous leukemia cells K562, but not in other tumor cells such as epidermoid carcinoma.
仅用于科研。不用于诊断过程。未经明确授权不得转售。
篇参考文献 (0)
生物信息学
蛋白别名: DKFZp761P1010; mNOK; NOK kinase; Novel oncogene with kinase domain; oncogene with kinase-domain; Protein PK-unique; receptor protein tyrosine kinase; oncogenic protein; Serine/threonine/tyrosine kinase 1; Tyrosine-protein kinase STYK1; unnamed protein product
基因别名: 9130025L13; AI326477; NOK; RGD1564211; STYK1; SuRTK106
UniProt ID: (Human) Q6J9G0, (Mouse) Q6J9G1
Entrez Gene ID: (Human) 55359, (Rat) 500340, (Mouse) 243659